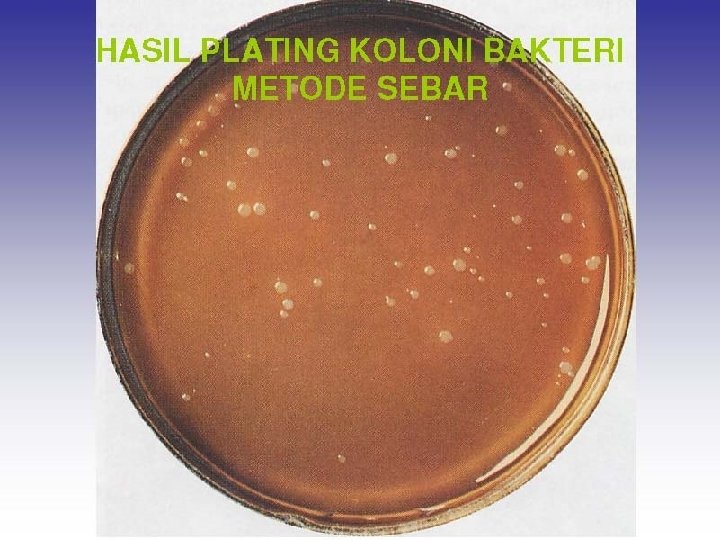
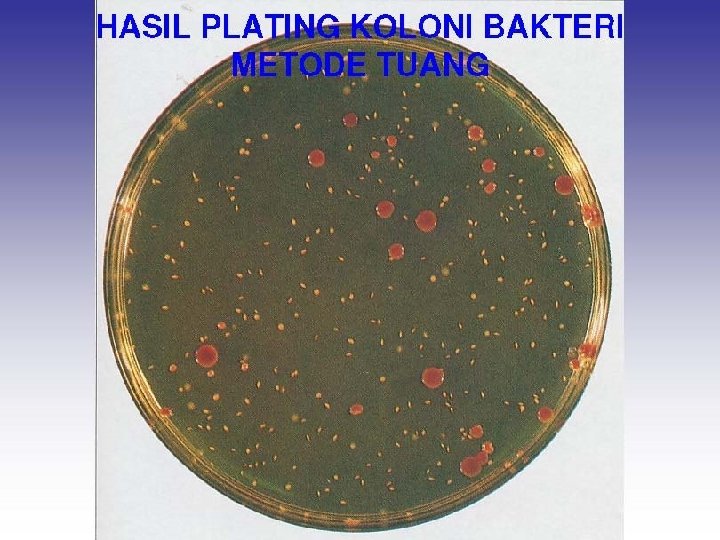

Isolasi Koloni dari Kultur Campuran Transfer Kultur Secara

- Slides: 23
Isolasi Koloni dari Kultur Campuran Transfer Kultur Secara Aseptik Praktikum 1 Isolasi Kultur Murni Pewarnaan diferensial Karakteristik Biakan Mikroorganisme
1. Transfer Kultur Secara Aseptik Alat dan Bahan • Kultur cair biakan bakteri • Kultur agar miring biakan bakteri • Medium agar plate biakan bakteri • Tabung reaksi berisi kaldu nutrisi • Tabung reaksi berisi agar Na • Jarum penanam • Pembakar bunsen
1. Transfer Kultur Secara Aseptik • Transfer medium cair ke kaldu nutrisi
1. Transfer Kultur Secara Aseptik • Transfer agar miring ke agar miring lainnya
1. Transfer Kultur Secara Aseptik • Transfer agar plate ke agar miring
2. Isolasi Dari Kultur Campuran Alat dan Bahan • Kultur Campuran 24 -48 jam • Media agar Na • Pembakar bunsen • Jarum penanam • Batang gelas L • Alkhohol 95% • Cawan Petri
2. Isolasi Dari Kultur Campuran • Streak Plate Ambil suspensi bakteri dengan jarum Goreskan pada medium Inkubasi 36 jam 25/27 o Celcius
2. Isolasi Dari Kultur Campuran • Spread Plate Rendam batang gelas L dalam alkhohol Tumpahkan suspensi bakteri pada agar dalam cawan petri Batang gelas L yang telah direndam dibakar 10 -15 detik Biakan bakteri disebarkan dengan menggesekan batang gelas L ke semua arah Inkubasi 36 jam 25/27 o Celcius
2. Isolasi Dari Kultur Campuran • Pour Plate
2. Isolasi Dari Kultur Campuran • Pour Plate
3. Isolasi kultur Murni Pindahkan koloni dari percobaan sebelumnya ke agar miring secara aseptik Inkubasi 36 jam 25/27 o Celcius
5. Karakteristik Biakan Mikroorganisme Alat dan Bahan • Agar nutrisi • Gelatin Nutrisi • Kaldu nutrisi • Koloni bakteri • Jarum inokulasi • Pembakar bunsen
5. Karakteristik Biakan Mikroorganisme Inokulasi setiap media Inkubasi 36 jam 25/27 o. C Amati pertumbuhan mikroorganisme dengan melihat karakteristik mikroorganisme
5. Karakteristik Biakan Mikroorganisme Inokulasi setiap media : • Agar nutrisi cawan petri : Gesek • Agar nutrisi miring : gores satu garis tunggal • Kaldu nutrisi : Goyang jarum beberapa kali • Gelatin nutrisi : Stab • Agar nutrisi tegak : stab
5. Karakteristik Biakan Mikroorganisme
5. Karakteristik Biakan Mikroorganisme
5. Pewarnaan Sederhana Pewarnaan positif • Bila menggunakan biakan cair maka pindahkan setetes biakan dengan pipet tetes atau dapat juga dipindahkan dengan jarum inokulum. Jangan lupa biakan dikocok terlebih dahulu. Jika digunakan biakan padat, maka biakan dipindahkan dengan jarum inokulum, satu ulasan saja kemudian diberi akuades dan disebarkan supaya sel merata. • Keringkan ulasan tersebut sambil memfiksasinya dengan api bunsen (lewatkan di atas api 2 -3 kali) • Setelah benar-benar kering dan tersebar selanjutnya ditetesi dengan pewarna (dapat digunakan Methylen blue, Safranin, Crystal Violet) dan tunggu kurang lebih 30 detik. • Cuci dengan akuades kemudian keringkan dengan kertas tissue • Periksa dengan mikroskop (perbesaran 100 x 10).
5. Pewarnaan Sederhana
5. Pewarnaan Sederhana Pewarnaan negatif • Ambil dua object glass, teteskan nigrosin atau tinta cina di ujung kanan salah satu object glass • Biakan diambil lalu diulaskan atau diteteskan dalam tetesan nigrosin tadi, lalu dicampurkan • Tempelkan sisi object glass yang lain kemudian gesekkan ke samping kiri • Biarkan preparat mengering di udara, jangan difiksasi atau dipanaskan di atas api.
5. Pewarnaan Sederhana
5. Pewarnaan Sederhana